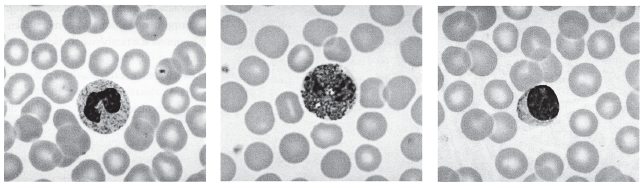
Enunciado 2642240-1
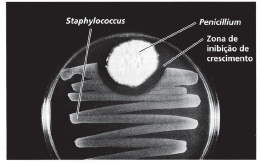
Enunciado 2642236-1

Foram encontradas 65 questões.
Parte do ciclo de vida do Plasmodium falciparum, agente causador da malária, ocorre no interior de hemácias do hospedeiro intermediário, contaminado pela picada do mosquito transmissor.
Provas

Fotografias de um esfregaço sanguíneo.
As hemácias, que constituem a proporção menor de células em um esfregaço sanguíneo, são células nucleadas e de longa durabilidade.
Provas
Fotografias de um esfregaço sanguíneo.
A morfologia do núcleo e granulações citoplasmáticas são critérios para a identificação das células brancas do sangue, os leucócitos.
Provas

A ilustração esquematiza um experimento clássico no estudo da hereditariedade.
As estratégias metodológicas utilizadas por Mendel, em seu famoso experimento, contemplam características essenciais ao trabalho em laboratório, como observação, organização, disciplina e fidelidade no registro dos dados experimentais, entre outras.
Provas

A ilustração esquematiza um experimento clássico no estudo da hereditariedade.
A relação numérica entre ervilhas lisas e rugosas, na F2, contribuiu para a associação da herança biológica a fatores particulares, hoje reconhecidos como genes.
Provas

A descoberta da penicilina por Alexander Fleming, em 1928, tornou-se o marco do uso medicinal de produtos naturais microbianos e revolucionou a medicina e o tratamento de certas infecções. A substância é produzida pelo fungo Penicillium notatum, que está apresentado na ilustração.
Os fungos são organismos que, em função de certas características do seu metabolismo, ocupam a posição de produtores na grande teia da vida.
Provas
A descoberta da penicilina por Alexander Fleming, em 1928, tornou-se o marco do uso medicinal de produtos naturais microbianos e revolucionou a medicina e o tratamento de certas infecções. A substância é produzida pelo fungo Penicillium notatum, que está apresentado na ilustração.
Os produtos naturais microbianos, referidos no texto, exemplificam um tipo de relação ecológica caracterizada como parasitismo.
Provas

“Zequinha está com febre e sua mãe aconselha-se com a irmã. Ela comenta que seu filho teve algo parecido e lhe recomendaram um remédio ótimo. Passa os comprimidos para Zequinha, que tem uma melhora súbita, mas logo cai de cama outra vez.”
A narrativa faz parte de uma cartilha sobre o uso correto de antibióticos, elaborada por pesquisadores do Instituto Nacional de Ciência e Tecnologia de Fármacos e Medicamentos (INCT- Inofar). (ZEQUINHA..., 2011, p. 65).
O diagnóstico laboratorial de uma doença causada por bactérias se limita ao uso da microscopia óptica.
Provas

“Zequinha está com febre e sua mãe aconselha-se com a irmã. Ela comenta que seu filho teve algo parecido e lhe recomendaram um remédio ótimo. Passa os comprimidos para Zequinha, que tem uma melhora súbita, mas logo cai de cama outra vez.”
A narrativa faz parte de uma cartilha sobre o uso correto de antibióticos, elaborada por pesquisadores do Instituto Nacional de Ciência e Tecnologia de Fármacos e Medicamentos (INCT- Inofar). (ZEQUINHA..., 2011, p. 65).
A recaída de Zequinha, personagem do texto da cartilha, deve ser atribuída ao uso inadequado do medicamento, por seleção de linhagens resistentes ou por sensibilidade diferenciada das bactérias a diferentes antibióticos.
Provas

“Zequinha está com febre e sua mãe aconselha-se com a irmã. Ela comenta que seu filho teve algo parecido e lhe recomendaram um remédio ótimo. Passa os comprimidos para Zequinha, que tem uma melhora súbita, mas logo cai de cama outra vez.”
A narrativa faz parte de uma cartilha sobre o uso correto de antibióticos, elaborada por pesquisadores do Instituto Nacional de Ciência e Tecnologia de Fármacos e Medicamentos (INCT- Inofar). (ZEQUINHA..., 2011, p. 65).
Os antibióticos devem ser prescritos para o tratamento de infecções causadas por vírus.
Provas
Caderno Container